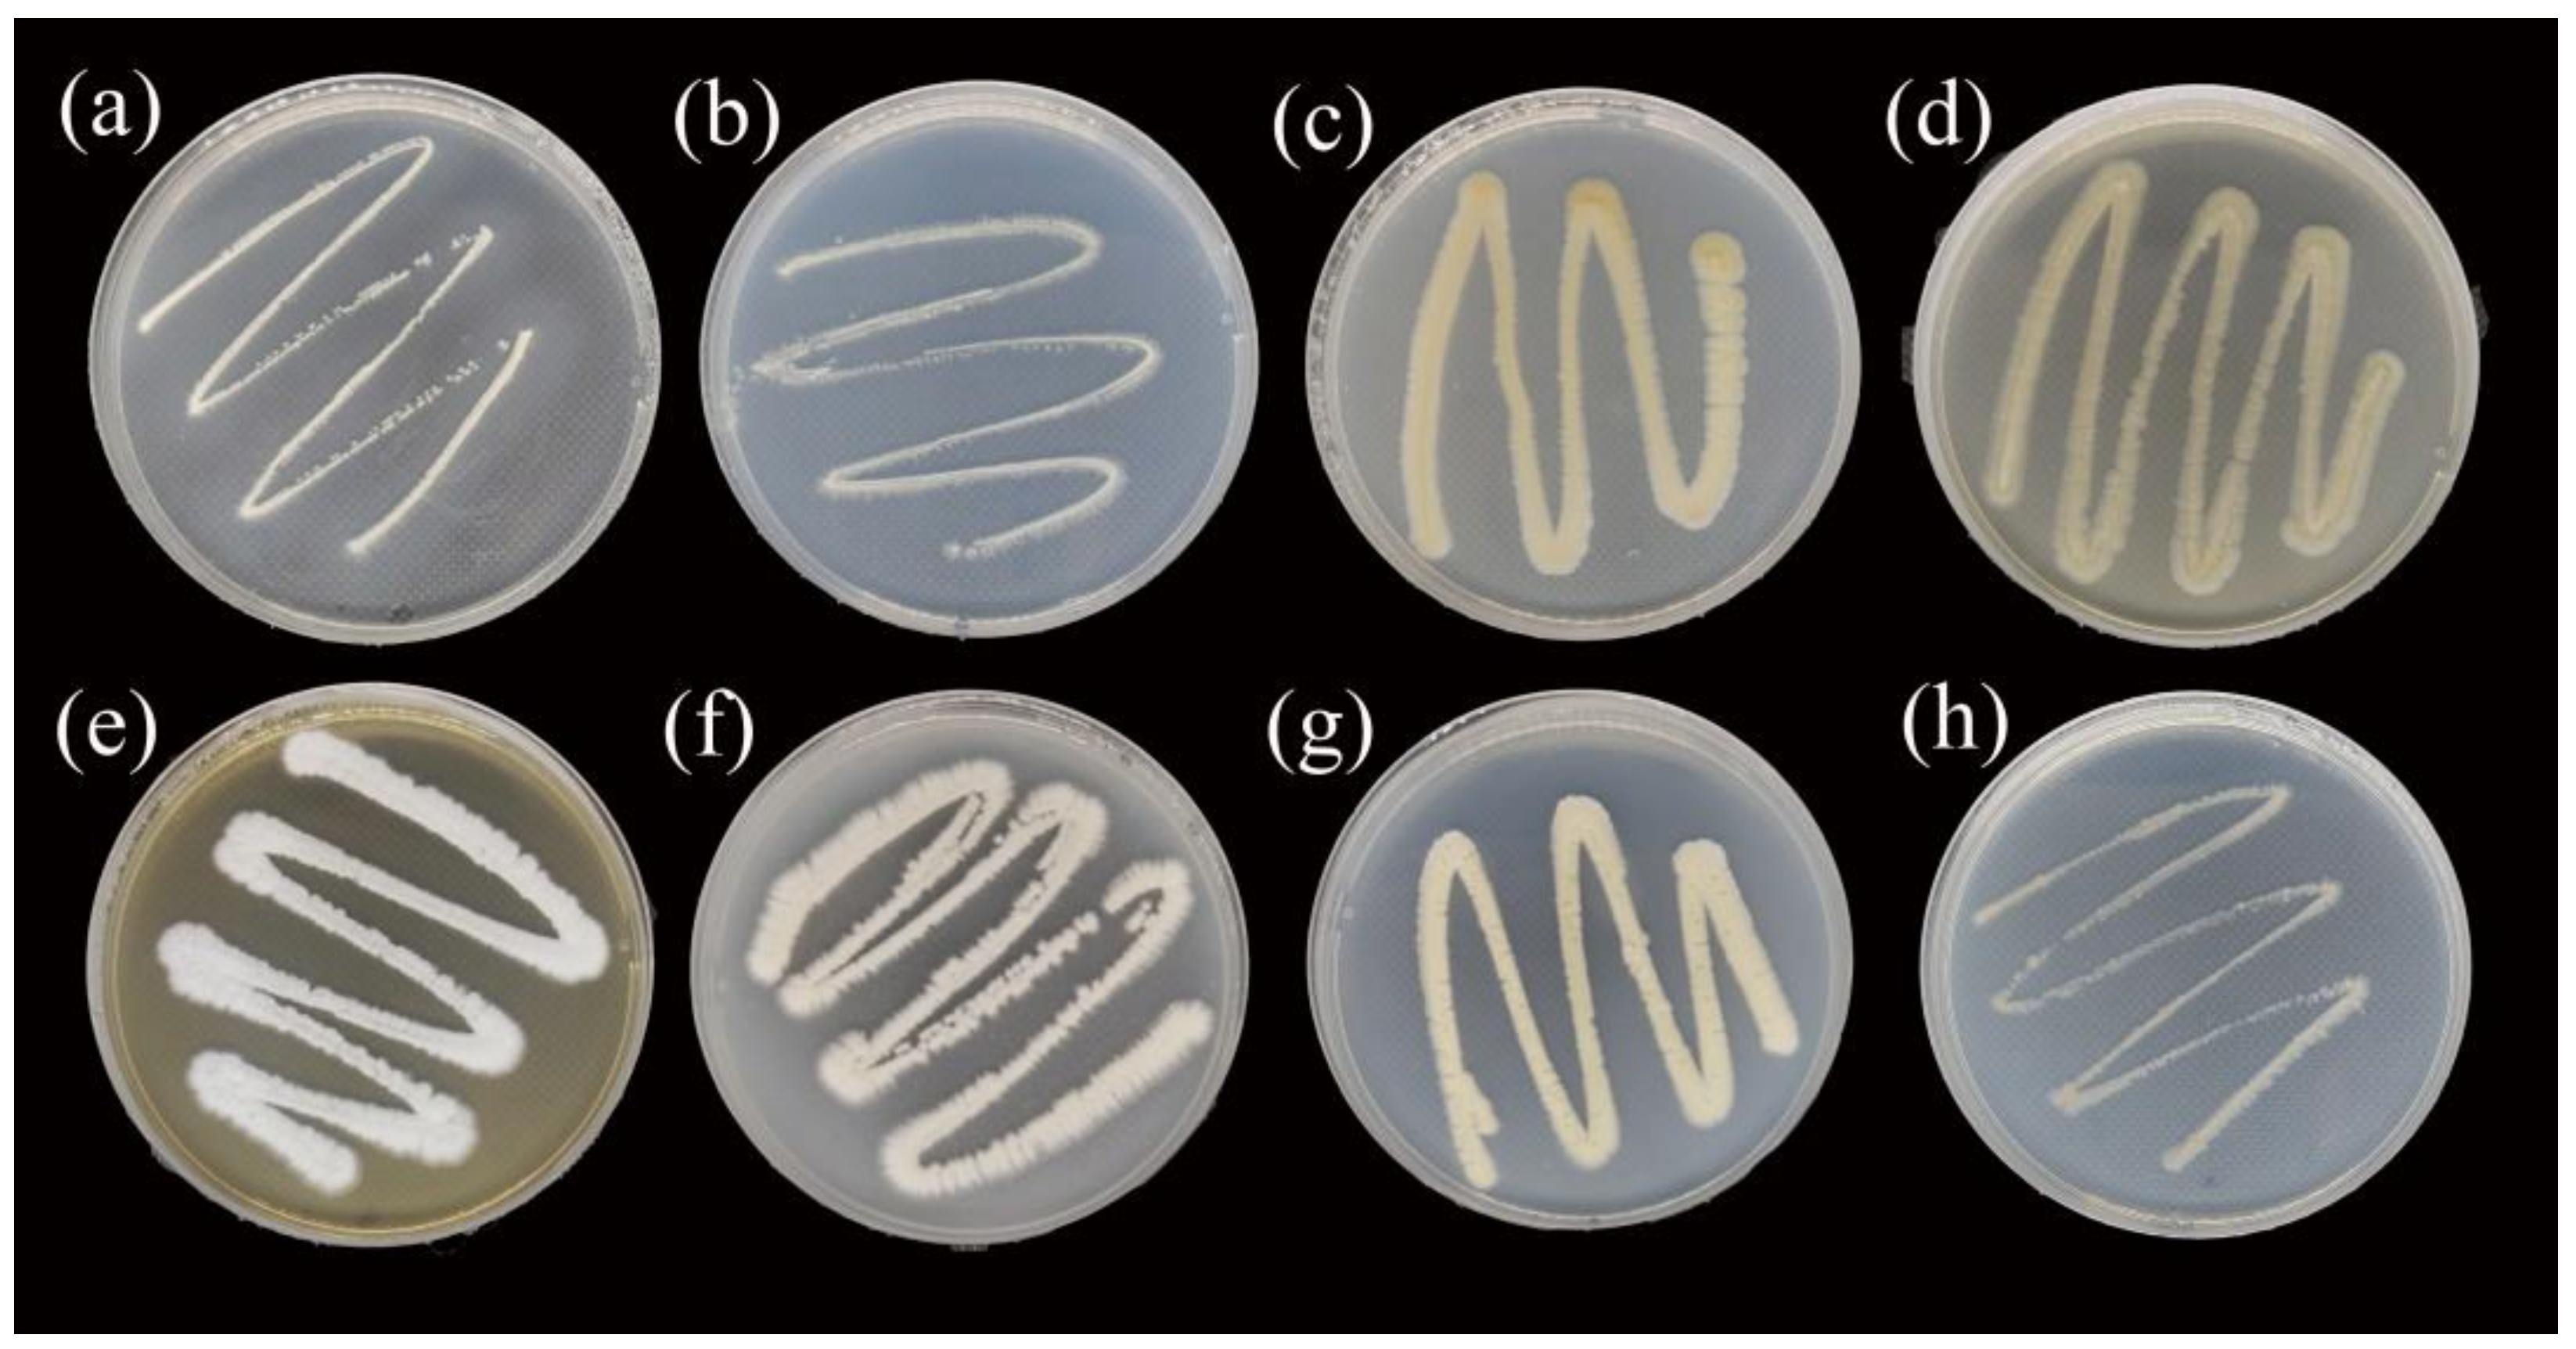
Forests 15 02124 g001

Biocontrol Potential of Streptomyces Strain FY4 Against Heterobasidion Root Rot Pathogen In Vitro
Abstract
1. Introduction
2. Materials and Methods
2.1. Streptomyces Strain FY4 and Fungal Pathogens
2.2. Cultivation and Characterization of Strain FY4
2.3. Phylogenetic Analyses of Strain FY4
2.4. Inhibitory Effect of Strain FY4 Mycelium on Heterobasidion spp.
2.5. Inhibitory Effect of Strain FY4 Fermentation Broth on Fungal Pathogen
2.5.1. Preparation of FY4 Fermentation Broth and LC-MS/MS Analysis
2.5.2. Inhibitory Effect of Strain FY4 Fermentation on Mycelial Growth of Fungal Pathogens
experiment group)/(Colony diameter of control group − 8) × 100%
2.5.3. Inhibition of Strain FY4 on Spore Germination of Heterobasidion spp.
2.6. Statistical Analysis
3. Results
3.1. Characterization of Strain FY4
3.2. Molecular Identification of Strain FY4
3.3. Inhibitory Effect of S. blastmyceticus FY4 Mycelium on Heterobasidion spp. Mycelial Growth
3.4. Inhibition of Strain FY4 Fermentation Broth on Mycelial Growth and Spore Germination of Heterobasidion spp.
4. Discussion
5. Conclusions
Supplementary Materials
Author Contributions
Funding
Data Availability Statement
Conflicts of Interest
References
- Dai, Y.-C.; Korhonen, K. Heterobasidion annosum Group S Identified in North-Eastern China. For. Pathol. 1999, 29, 273–279. [Google Scholar] [CrossRef]
- Ota, Y.; Tokuda, S.; Buchanan, P.K.; Hattori, T. Phylogenetic Relationships of Japanese Species of Heterobasidion—H. annosum sensu lato and an Undetermined Heterobasidion sp. Mycologia 2006, 98, 717–725. [Google Scholar] [CrossRef] [PubMed]
- Hodges, C.S. Heterobasidion annosum. Biology, Ecology, Impact and Control. Plant Pathol. 1999, 48, 564–565. [Google Scholar] [CrossRef]
- Li, X. Biological Control on Heterobasidion parviporum and Its Decay in China. Master’s Thesis, Beijing Forestry University, Beijing, China, 2014. [Google Scholar]
- Asiegbu, F.O.; Adomas, A.; Stenlid, J. Conifer Root and Butt Rot Caused by Heterobasidion annosum (Fr.) Bref. s.l. Mol. Plant Pathol. 2005, 6, 395–409. [Google Scholar] [CrossRef]
- Drenkhan, T.; Sutela, S.; Veeväli, V.; Vainio, E.J. Phlebiopsis gigantea Strains from Estonia Show Potential as Native Biocontrol Agents against Heterobasidion Root Rot and Contain Diverse dsRNA and ssRNA Viruses. Biol. Control. 2022, 167, 104837. [Google Scholar] [CrossRef]
- Pellicciaro, M.; Lione, G.; Ongaro, S.; Gonthier, P. Comparative Efficacy of State-of-the-Art and New Biological Stump Treatments in Forests Infested by the Native and the Alien Invasive Heterobasidion Species Present in Europe. Pathogens 2021, 10, 1272. [Google Scholar] [CrossRef]
- Oliva, J.; Zhao, A.; Zarei, S.; Sedlák, P.; Stenlid, J. Effect of Temperature on the Interaction between Phlebiopsis gigantea and the Root-Rot Forest Pathogen Heterobasidion spp. For. Ecol. Manag. 2015, 340, 22–30. [Google Scholar] [CrossRef]
- Ronnberg, J.; Sidorov, E.; Petrylaite, E. Efficacy of Different Concentrations of Rotstop (R) and Rotstop (R) S and Imperfect Coverage of Rotstop (R) S against Heterobasidion spp. Spore Infections on Norway Spruce Stumps. For. Pathol. 2006, 36, 422–433. [Google Scholar] [CrossRef]
- Vaario, L.-M.; Asamizu, S.; Sarjala, T.; Matsushita, N.; Onaka, H.; Xia, Y.; Kurokochi, H.; Morinaga, S.-I.; Huang, J.; Zhang, S.; et al. Bioactive Properties of Streptomyces May Affect the Dominance of Tricholoma matsutake in Shiro. Symbiosis 2020, 81, 1–13. [Google Scholar] [CrossRef]
- Froes, A.; Macrae, A.; Rosa, J.; Franco, M.; Souza, R.; Soares, R.; Coelho, R. Selection of a Streptomyces Strain Able to Produce Cell Wall Degrading Enzymes and Active against Sclerotinia sclerotiorum. J. Microbiol. 2012, 50, 798–806. [Google Scholar] [CrossRef]
- Qaddoumi, S.Q.; El-Banna, N.M. Isolation and Characterization of Actinomycetes with Antimicrobial Activity from the Soil and the Effect of the Environmental Factors on Their Antimicrobial Activity. Afr. J. Microbiol. Res. 2018, 12, 849–856. [Google Scholar] [CrossRef]
- Jung, S.J.; Kim, N.K.; Lee, D.-H.; Hong, S.I.; Lee, J.K. Screening and Evaluation of Streptomyces Species as a Potential Biocontrol Agent against a Wood Decay Fungus, Gloeophyllum trabeum. Mycobiology 2018, 46, 138–146. [Google Scholar] [CrossRef] [PubMed]
- Jia, R.; Xiao, K.; Yu, L.; Chen, J.; Hu, L.; Wang, Y. A Potential Biocontrol Agent Streptomyces tauricus XF for Managing Wheat Stripe Rust. Phytopathol. Res. 2023, 5, 14. [Google Scholar] [CrossRef]
- Silva, G.D.C.; Kitano, I.T.; Ribeiro, I.A.D.F.; Lacava, P.T. The Potential Use of Actinomycetes as Microbial Inoculants and Biopesticides in Agriculture. Front. Soil Sci. 2022, 2, 833181. [Google Scholar] [CrossRef]
- Figueiredo de Vasconcellos, R.L.; Bran Nogueira Cardoso, E.J. Rhizospheric Streptomycetes as Potential Biocontrol Agents of Fusarium and Armillaria Pine Rot and as PGPR for Pinus taeda. Biocontrol 2009, 54, 807–816. [Google Scholar] [CrossRef]
- Zhou, S.; Zhou, Y.; Li, C.; Wu, W.; Xu, Y.; Xia, W.; Huang, D.; Huang, X. Identification and Genomic Analyses of a Novel Endophytic Actinobacterium Streptomyces endophytica sp. nov. with Potential for Biocontrol of Yam Anthracnose. Front. Microbiol. 2023, 14, 1139456. [Google Scholar] [CrossRef]
- Lehr, N.-A.; Schrey, S.D.; Hampp, R.; Tarkka, M.T. Root Inoculation with a Forest Soil Streptomycete Leads to Locally and Systemically Increased Resistance against Phytopathogens in Norway Spruce. New Phytol. 2008, 177, 965–976. [Google Scholar] [CrossRef]
- Tarkka, M.T.; Lehr, N.A.; Hampp, R.; Schrey, S.D. Plant Behavior upon Contact with Streptomycetes. Plant Signal. Behav. 2008, 3, 917–919. [Google Scholar] [CrossRef]
- Garbelotto, M.; Gonthier, P. Biology, Epidemiology, and Control of Heterobasidion Species Worldwide. Annu. Rev. Phytopathol. 2013, 51, 39–59. [Google Scholar] [CrossRef]
- Shirling, E.B.; Gottlieb, D. Methods for Characterization of Streptomyces Species. Int. J. Syst. Bacteriol. 1966, 16, 313–340. [Google Scholar] [CrossRef]
- Guo, L. Diversity of Symbiotic Actinomycetes from Camponotus janponicus Mayr and Their Antibacterial Activity. Master’s Thesis, Northeast Agricultural University, Harbin, China, 2016. [Google Scholar]
- Delbari, Y.; Mohassel, Y.; Kakaei, E.; Bahrami, Y. Identification and Anti-Bacterial Property of Endophytic Actinobacteria from Thymes kotschyanus, Allium hooshidaryae, and Cerasus microcarpa. Sci. Rep. 2023, 13, 13145. [Google Scholar] [CrossRef] [PubMed]
- Lu, Z. Bacterial Taxonomy; Wuhan University Press: Wuhan, China, 1994. [Google Scholar]
- Yokota, A.; Tamura, T.; Hasegawa, T.; Huang, L.H. Catenuloplanes japonicus gen. nov., sp. nov., nom. rev., a New Genus of the Order Actinomycetales. Int. J. Syst. Bacteriol. 1993, 43, 805–812. [Google Scholar] [CrossRef]
- Guo, Y.; Zheng, W.; Rong, X.; Huang, Y. A Multilocus Phylogeny of the Streptomyces griseus 16S rRNA Gene Clade: Use of Multilocus Sequence Analysis for Streptomycete Systematics. Int. J. Syst. Evol. Microbiol. 2008, 58, 149–159. [Google Scholar] [CrossRef] [PubMed]
- Janisiewicz, W.J. Biocontrol of Postharvest Diseases of Apples with Antagonist Mixtures. Phytopathology 1988, 78, 194–198. [Google Scholar] [CrossRef]
- Zolciak, A.; Sikora, K.; Wrzosek, M.; Damszel, M.; Sierota, Z. Why Does Phlebiopsis gigantea Not Always Inhibit Root and Butt Rot in Conifers? Forests 2020, 11, 129. [Google Scholar] [CrossRef]
- Shimoi, S.; Inoue, K.; Kitagawa, H.; Yamasaki, M.; Tsushima, S.; Park, P.; Ikeda, K. Biological Control for Rice Blast Disease by Employing Detachment Action with Gelatinolytic Bacteria. Biol. Control. 2010, 55, 85–91. [Google Scholar] [CrossRef]
- Donald, L.; Pipite, A.; Subramani, R.; Owen, J.; Keyzers, R.A.; Taufa, T. Streptomyces: Still the Biggest Producer of New Natural Secondary Metabolites, a Current Perspective. Microbiol. Res. 2022, 13, 418–465. [Google Scholar] [CrossRef]
- Kasanen, R.; Awan, H.U.M.; Zarsav, A.; Sun, H.; Asiegbu, F.O. Chapter 23—Forest Tree Disease Control and Management. In Forest Microbiology; Asiegbu, F.O., Kovalchuk, A., Eds.; Academic Press: New York, NY, USA, 2022; pp. 425–462. [Google Scholar]
- Sharmin, T.; Rahman, M.A.; Anisuzzaman, A.S.M.; Islam, M.A.-U. Antimicrobial and Cytotoxic Activities of Secondary Metabolites Obtained from a Novel Species of Streptomyces. Bangladesh Pharm. J. 2013, 16, 15–19. [Google Scholar] [CrossRef]
- Bluemomycin, a New Naphthoquinone Derivative from Streptomyces sp. with Antimicrobial and Cytotoxic Properties|Biotechnology Letters. Available online: https://link.springer.com/article/10.1007/s10529-021-03089-y (accessed on 29 October 2024).
- Futuro, D.O.; Ferreira, P.G.; Nicoletti, C.D.; Borba-Santos, L.P.; Silva, F.C.D.; Rozental, S.; Ferreira, V.F. The Antifungal Activity of Naphthoquinones: An Integrative Review. An. Acad. Brasil. Ciênc. 2018, 90, 1187–1214. [Google Scholar] [CrossRef]
- Schrey, S.D.; Erkenbrack, E.; Früh, E.; Fengler, S.; Hommel, K.; Horlacher, N.; Schulz, D.; Ecke, M.; Kulik, A.; Fiedler, H.-P.; et al. Production of Fungal and Bacterial Growth Modulating Secondary Metabolites Is Widespread among Mycorrhiza-Associated Streptomycetes. BMC Microbiol. 2012, 12, 164. [Google Scholar] [CrossRef]
- Misato, T.; Ishii, I.; Asakawa, M.; Fukunaga, K. Antibiotics as Protectant Fungicides against Rice Blast. Jpn. J. Phytopathol. 1958, 23, 219–224. [Google Scholar] [CrossRef]
- Ni, M.; Wu, Q.; Wang, H.; Liu, W.; Hu, B.; Zhang, D.; Zhao, J.; Liu, D.; Lu, C. Identification of a Novel Strain, Streptomyces blastmyceticus JZB130180, and Evaluation of Its Biocontrol Efficacy against Monilinia fructicola. J. Zhejiang Univ. Sci. B 2019, 20, 84–94. [Google Scholar] [CrossRef] [PubMed]
- Kang, M.-K.; Kim, M.-H.; Liu, M.-J.; Jin, C.Z.; Park, S.H.; Lee, J.M.; Kim, J.; Park, D.-J.; Park, H.-R.; Kim, Y.H.; et al. Nematicidal Activity of Teleocidin B4 Isolated from Streptomyces sp. Against Pine Wood Nematode, Bursaphelenchus xylophilus. Pest Manag. Sci. 2021, 77, 1607–1615. [Google Scholar] [CrossRef] [PubMed]

Disclaimer/Publisher’s Note: The statements, opinions and data contained in all publications are solely those of the individual author(s) and contributor(s) and not of MDPI and/or the editor(s). MDPI and/or the editor(s) disclaim responsibility for any injury to people or property resulting from any ideas, methods, instructions or products referred to in the content. |
© 2024 by the authors. Licensee MDPI, Basel, Switzerland. This article is an open access article distributed under the terms and conditions of the Creative Commons Attribution (CC BY) license (https://creativecommons.org/licenses/by/4.0/).
Share and Cite
Li, Y.; Li, X.; Geng, L.; Li, S.; Gao, Z.; Huang, L.; Vaario, L.-M.; Sun, H. Biocontrol Potential of Streptomyces Strain FY4 Against Heterobasidion Root Rot Pathogen In Vitro. Forests 2024, 15, 2124. https://doi.org/10.3390/f15122124
Li Y, Li X, Geng L, Li S, Gao Z, Huang L, Vaario L-M, Sun H. Biocontrol Potential of Streptomyces Strain FY4 Against Heterobasidion Root Rot Pathogen In Vitro. Forests. 2024; 15(12):2124. https://doi.org/10.3390/f15122124
Chicago/Turabian StyleLi, Yilin, Xuehai Li, Li Geng, Shijie Li, Ziwen Gao, Lin Huang, Lu-Min Vaario, and Hui Sun. 2024. "Biocontrol Potential of Streptomyces Strain FY4 Against Heterobasidion Root Rot Pathogen In Vitro" Forests 15, no. 12: 2124. https://doi.org/10.3390/f15122124
APA StyleLi, Y., Li, X., Geng, L., Li, S., Gao, Z., Huang, L., Vaario, L.-M., & Sun, H. (2024). Biocontrol Potential of Streptomyces Strain FY4 Against Heterobasidion Root Rot Pathogen In Vitro. Forests, 15(12), 2124. https://doi.org/10.3390/f15122124

